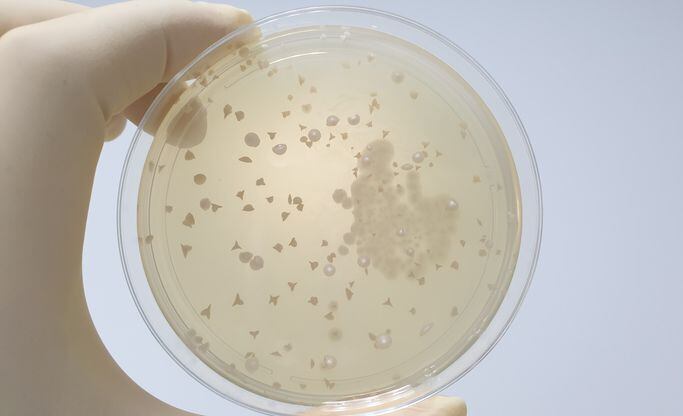

The research was published recently in the journal Frontiers in Psychiatry. It was conducted by a team or researchers associated with the University of California San Diego.
Loneliness and wisdom defined
The researchers noted that loneliness has both a periodic and a chronic dimension. It is the latter they were concerned with. “Persistent or chronic loneliness, rather than short-term fluctuations—is considered to be biologically toxic. . . . Both loneliness and social disconnectedness are independently associated with worse physical health; however, the mechanisms responsible are not fully understood,” they wrote.
Wisdom, on the other hand, has a number of dimensions, all of which seem to contribute to better physical health.
“The affective dimension refers to the presence of positive emotions and behaviors toward others, such as empathy and acts of compassion. The reflective dimension is the ability to engage in reflective thinking and development of self-awareness. The cognitive dimension refers to one's knowledge about the world and comprehension of the deeper meaning of life events,” the authors wrote.
184 community dwelling individuals took part
To test how different levels of loneliness and wisdom might affect the gut microbiota the researchers recruited 184 community-dwelling participants whose age ranged from 28 to 97. They completed validated self-report-based measures of loneliness, wisdom, compassion, social support, and social engagement. Fecal samples were collected from the subjects and profiled using 16S rRNA sequencing.
The authors expected to find that people who self reported as being more persistently lonely would have less diverse gut microbiomes. Greater gut diversity is generally associated with better overall health.
More loneliness = less resilient gut
“As hypothesized, higher levels of loneliness and lower levels of compassion, wisdom, social support, and social engagement were associated with decreased phylogenetic richness and diversity of the gut microbiome. We further evaluated the multivariate relationship of alpha-diversity with psychosocial variables, and found that the PLS component comprising of all psychosocial variables were significantly associated with alpha-diversity. Wisdom and compassion were associated with both microbial diversity and microbial community structure and composition,” the authors wrote.
“A species-rich community may be less susceptible to invasion by exogenous pathogens and confer resilience and stability. It is possible that loneliness may result in decreased stability of the gut microbiome and, consequently, reduced resistance and resilience to stress-related disruptions, leading to downstream physiological effects such as systemic inflammation,” they added.
Expert: Intriguing addition to research mix
Dr Emeran Mayer, MD, of UCLA commented on the research in a blog posting. Dr Mayer said the results are not necessarily surprising, as persistent loneliness has generally been associated with negative emotional states, such as depression or higher stress levels, which have been shown to negatively affect the gut microbiome. Still, he said even with the study’s limitations, such as its cross sectional design and lack of diet information, it is an intriguing addition to the conversation.
“[T]he general observation that negative or positive emotional and behavioral states are translated from the brain into the diversity and abundances of our gut microbes, changes which in turn may negatively affect gut health, engage the activity of the gut-associated immune system and increase the risk for many chronic non-infectious diseases is intriguing. These exploratory findings, if confirmed, may have important public health implications and are definitely worthwhile to be pursued in future well designed studies,” Mayer wrote.
Source: Frontiers in Psychiatry
doi.org/10.3389/fpsyt.2021.648475
Association of Loneliness and Wisdom With Gut Microbial Diversity and Composition: An Exploratory Study
Authors: Nguyen TT, et al.